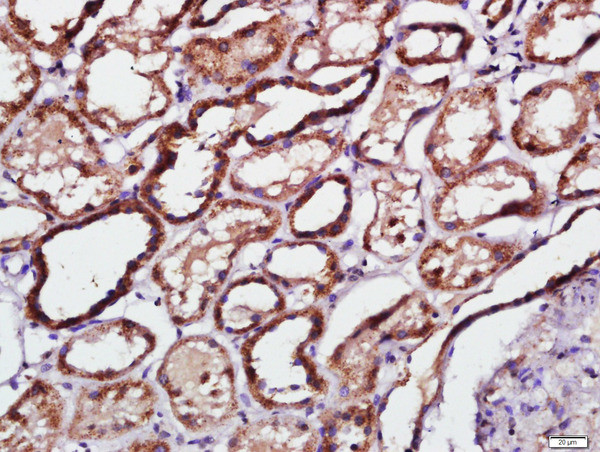
Phospho-PKR (Thr451) Antibody in Immunohistochemistry (Paraffin) (IHC (P))

Search
Bioss
Phospho-PKR (Thr451) Polyclonal Antibody
{{$productOrderCtrl.translations['antibody.pdp.commerceCard.promotion.promotions']}}
{{$productOrderCtrl.translations['antibody.pdp.commerceCard.promotion.viewpromo']}}
{{$productOrderCtrl.translations['antibody.pdp.commerceCard.promotion.promocode']}}: {{promo.promoCode}} {{promo.promoTitle}} {{promo.promoDescription}}. {{$productOrderCtrl.translations['antibody.pdp.commerceCard.promotion.learnmore']}}
图: 1 / 2
Phospho-PKR (Thr451) Antibody (BS-3336R) in IHC (P)


产品信息
BS-3336R
种属反应
宿主/亚型
分类
类型
抗原
偶联物
形式
浓度
纯化类型
保存液
内含物
保存条件
运输条件
靶标信息
EIF2AK2 (PKR) is one of 4 kinases that specifically phosphorylate Ser51 of translation initiation factor eIF2-alpha in response to various environmental stresses. EIF2AK2 plays a key role in antiviral defense mediated through its direct activation by double-stranded RNA produced by viral infection. PKR plays a key role in IFN induced-innate antiviral response, virus-induced apoptosis, cell growth & differentiation. PKR induces apoptosis by up-regulating Fas expression and mediates FADD/Caspase-8 death signaling pathway. Upon viral infection, it functions as a dual protein, sequentially activating both cell survival & cell death pathways using kinase independent and dependent strategies. PRKR regulates multiple pathways which include NF-kappaB activation, p53, p38, & PDGF signaling pathway. PKR has been implicated in tumor suppression & malignancy. To evade the antiviral effects of PKR, viruses have evolved multiple mechanisms, such as the inhibition of PKR by the non-structural protein (NS1) of the influenza virus. More recently, PKR has been implicated in several neurodegenerative diseases including Alzheimer, Huntington, and amyotrophic lateral sclerosis.
仅用于科研。不用于诊断过程。未经明确授权不得转售。
篇参考文献 (0)
生物信息学
蛋白别名: double stranded RNA activated protein kinase; dsRNA-activated kinase; EC 2.7.11.1; eIF-2 alpha; eIF-2A protein kinase 2; eIF2a Kinase; eukaryotic translation initiation factor 2 alpha kinase 2; Eukaryotic translation initiation factor 2-alpha kinase 2; IFN- type I-induced and dsRNA-activated kinase; IFN-induced and double-stranded RNA-activated kinase; Interferon-induced, double-stranded RNA-activated protein kinase; interferon-inducible elF2alpha kinase; Interferon-inducible RNA-dependent protein kinase; MGC126524; OTTHUMP00000201320; P1/eIF-2A protein kinase; p68 kinase; PKR; protein kinase R; Protein kinase RNA-activated; protein kinase, interferon inducible double stranded RNA dependent; protein kinase, interferon-inducible double stranded RNA dependent; protein phosphatase 1, regulatory subunit 83; Serine/threonine-protein kinase TIK; T-cell viral integration site; Tyrosine-protein kinase EIF2AK2
基因别名: 2310047A08Rik; 4732414G15Rik; AI467567; AI747578; EIF2AK1; EIF2AK2; PKR; PPP1R83; PRKR; Tik
UniProt ID: (Human) P19525, (Mouse) Q03963
Entrez Gene ID: (Human) 5610, (Mouse) 19106